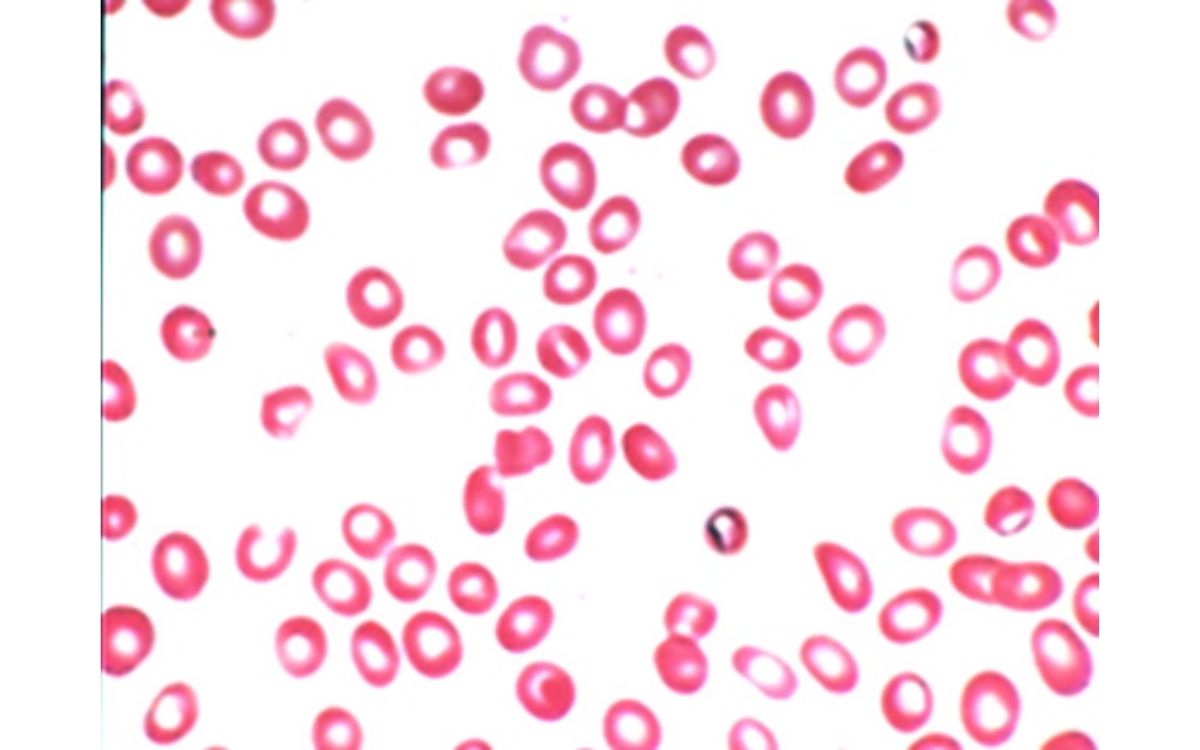

Apa itu Anemia?

Ilustrasi kondisi Normal vs Anemia. Sumber: Health Harvard.
Anemia adalah suatu kondisi di mana seseorang memiliki proporsi sel darah merah yang rendah di dalam tubuhnya. Alih-alih sebagai penyakit, kondisi ini sebetulnya adalah tanda – tanda atau gejala terhadap suatu kondisi yang dialami oleh individu tersebut.[1]
Sel darah merah adalah sel darah berbentuk seperti cakram yang befungsi untuk membawa oksigen ke organ dan jaringan tubuh. Kondisi ini terjadi ketika jumlah sel darah merah yang sehat di tubuh terlalu rendah.[2]
Setiap bagian tubuh membutuhkan pasokan oksigen yang cukup agar dapat berfungsi secara efektif. Oleh sebab itu, seseorang yang mengalami gejala anemia mengalami kondisi kelelahan dan sesak napas yang disebabkan oleh berkurangnya pengiriman oksigen ke organ dan jaringan vital tubuh.[2]
Sel darah merah mengandung protein kaya akan zat besi yang disebut hemoglobin. Protein tersebut mengikat oksigen di paru-paru Anda untuk selanjutnya membawa oksigen dan mengirimkannya ke seluruh tubuh Anda. Kondisi ini diukur berdasarkan jumlah hemoglobin dalam darah Anda.[2]
Menurut World Health Organization (WHO), seorang dikatakan mengalami kondisi ini apabila dinilai kadar hemoglobin (Hb) <12,0 g/dL pada wanita dan <13,0 g/dL pada pria. Namun perlu diperhatikan bahwa distribusi Hb pada individu normal memiliki nilai yang berbeda-beda tergantung pada jenis kelamin, suku, dan status fisiologis.[3]
Gejala Anemia

Ilustrasi seseorang terkena anemia.
Anemia menimbulkan gejala seperti kelelahan, berkurangnya kapasitas kerja fisik, dan sesak napas. Kondisi ini merupakan indikator adanya gizi buruk dan atau masalah kesehatan lainnya.[1]
Gejala anemia yang umum dan non-spesifik meliputi:[1]
- Lemas.
- Letih.
- Sesak nafas, terutama pada saat beraktivitas.
- Rasa nyeri pada dada.
- Anemia ringan mungkin tidak menunjukkan gejala.
Anemia berat dapat menyebabkan gejala yang lebih serius termasuk:[2]
- Lapisan mukosa pucat (di mulut, hidung dsb.).
- Pucat pada kulit dan bagian bawah kuku.
- Pernapasan dan detak jantung terasa cepat.
- Pusing saat berdiri.
- Lebih mudah memar.
Tipe Anemia
Terdapat banyak tipe kondisi ini. Walaupun seluruh tipe kondisi ini memiliki ciri jumlah sel darah merah yang rendah atau tidak dapat berfungsi sebagaimana fungsinya, terdapat perbedaan yang menjadi pembeda dalam penyebabnya, tingkat keparahan, dan cara menanggulanginya.[4]
Anemia dapat dikelompokkan berdasarkan nilai mean corpuscular volume (MCV). Nilai tersebut menunjukan rata – rata volume dari sel darah merah pada sampel. Nilai MCV yang rendah mengindikasikan anemia mikrositik, normal MCV menunjukan anemia normositik, dan MCV yang tinggi mengindikasikan makrositik.[5]
Masing – masing dari tipe tersebut memiliki penyebab yang beragam:
1. Anemia Mikrositik
Anemia Mikrositik adalah tipe anemia di mana sel darah merah yang bersirkulasi memiliki ukuran yang lebih kecil dibandingkan ukuran sel darah merah yang seharusnya. Penyebab paling umum dari anemia jenis ini adalah berkurangnya cadangan zat besi dalam tubuh yang mungkin disebabkan oleh berbagai alasan.[6]
Berbagai alasan penyebab berkurangnya cadangan zat besi dalam tubuh pada anemia mikrositik ini seperti: penurunan zat besi dalam makanan, buruknya penyerapan zat besi, peningkatan kebutuhan zat besi dalam situasi tertentu seperti kehamilan atau pemulihan dari trauma besar atau pembedahan. Selain itu, kelainan darah seperti talasemia dan sickle cell juga dapat menyebabkan anemia tipe ini.[6]
Gambar sel darah merah mikrositik anemia. Sumber: NCBI.
Baca Juga: Talasemia: Penyakit Kelainan Darah Bawaan & Cara Mencegahnya
2. Anemia Normositik
Pada anemia normositik, sel darah merah tidak cukup untuk memenuhi kebutuhan tubuh Anda. Kondisi inii berbeda dengan jenis anemia lainnya karena ukuran rata-rata dan kandungan hemoglobin sel darah merah biasanya berada dalam batas normal. Sel darah merah biasanya tampak mirip dengan sel normal jika diperiksa secara mikroskopis.[7]
Sebagian besar kondisi ini disebabkan oleh karena adanya penyakit lain. Hal ini mungkin disebabkan oleh adanya peradangan, neoplasma, gagal ginjal, kegagalan endokrin (hipotiroidisme, hipopituitarisme), kelainan hemoglobin varian, kegagalan sumsum tulang (anemia aplastik, infiltrasi), kehilangan darah akut, dan rematik polimialgia.[7]
3. Anemia Makrositik
Anemia makrositik mengacu pada makrositosis (rata-rata MCV lebih besar dari 100 fL). Kondisi ini terjadi ketika sumsum tulang membuat sel darah merah lebih besar dari ukuran biasanya. Tipe ini dibagi menjadi dua bentuk, megaloblastik (neutrofil hipersegmentasi) dan non-megaloblastik.[8]
3.1. Anemia Megaloblastik
Anemia megaloblastik terjadi akibat kekurangan asam folat dan vitamin B12. Defisiensi folat dapat disebabkan oleh berkurangnya asupan, penyalahgunaan alkohol, malnutrisi, dan malabsorpsi (disebabkan keturunan atau efek dari obat-obatan seperti cholestyramine atau metformin).[8]
Defisiensi vitamin B12 muncul akibat berkurangnya asupan (malnutrisi), malabsorpsi (gastritis atrofi baik autoimun maupun non-autoimun akibat Helicobacter pylori atau sindrom Zollinger-Ellison, infeksi cacing pita Diphyllobothrium), dan sebagainya.[8]
3.2. Anemia Non-Megaloblastik
Anemia non-megaloblastik terjadi karena tidak adanya hipersegmentasi neutrofil. Hipersegmentasi neutrofil dapat didefinisikan sebagai adanya neutrofil dengan enam lobus atau lebih.[9] Hal ini dapat terjadi pada berbagai keadaan seperti konsumsi alkohol (toksisitas sel darah merah), hipotiroidisme dan penyakit hati (akibat pengendapan lipid di membran sel).[8]

Gambar sel darah merah anemia makrositik. Sumber: NCBI.
Prevalensi Anemia di Indonesia
Anemia adalah masalah kesehatan global yang tersebar luas yang menjadi salah satu penyebab kesehatan yang buruk, peningkatan morbiditas dan mortalitas, serta biaya kesehatan tinggi. Negara-negara berpendapatan rendah dan menengah ke bawah adalah yang paling rentan terhadap kondisi ini, terutama bagi orang-orang yang tinggal di pedesaan, memiliki rumah tangga miskin, dan tidak memiliki akses ke pendidikan formal.[10]
Pada tahun 2021, prevalensi global anemia pada semua usia adalah 24,3%, atau setara dengan 1,92 miliar kasus. Berdasarkan usia, jenis kelamin, dan geografi, anak-anak di bawah 5 tahun, perempuan, dan negara-negara di Afrika sub-Sahara dan Asia Selatan yang paling banyak mengalami kondisi ini.[10]
Berdasarkan Riset Kesehatan Dasar (RISKESDAS) Kementerian Kesehatan Republik Indonesia (KEMENKES RI) tahun 2018, prevalensi anemia di Indonesia sendiri adalah 23,7%. Pada ibu hamil, hampir setengahnya mengalami kondisi ini dengan prevalensi sebesar 48,9%.[11]

Prevalensi anemia pada ibu hamil menurut karakteristik.[11]
Dampak Risiko Anemia
Jika tidak ditangani dalam jangka waktu lama, kondisi ini dapat menyebabkan kegagalan multiorgan dan bahkan kematian. Ibu hamil dengan kondisi ini bisa saja melahirkan prematur dan melahirkan bayi dengan berat badan rendah. Anemia saat hamil juga meningkatkan risiko kondisi ini pada bayi dan peningkatan terjadinya kehilangan darah saat hamil.[1]
Pengobatan dan pencegahan anemia bergantung pada penyebab yang mendasari kondisi tersebut. Ada banyak cara efektif untuk mengobati dan mencegah kondisi ini.[2]
Pencegahan dan Penanganan Anemia
Ada beberapa cara untuk membantu mencegah dan menangani anemia dalam kehidupan sehari-hari, termasuk mengonsumsi makanan yang sehat dan beragam, serta berkonsultasi dengan penyedia layanan kesehatan sejak dini jika Anda mengalami gejala kondisi ini.[2]
Untuk menjaga pola makan yang sehat dan beragam, Anda dapat melakukan hal berikut ini:[2]
- Mengonsumsi makanan yang kaya akan zat besi, termasuk daging merah tanpa lemak, ikan, unggas, kacang-kacangan (misalnya lentil dan kacang-kacangan), sereal yang diperkaya dan sayuran berdaun hijau tua.
- Mengonsumsi makanan yang kaya akan folat, vitamin B12, vitamin A, dan nutrisi lainnya.
- Mengonsumsi makanan kaya vitamin C (seperti buah-buahan dan sayur-sayuran) yang membantu tubuh menyerap zat besi.
- Menghindari makanan yang memperlambat penyerapan zat besi bila mengonsumsi makanan kaya zat besi, seperti dedak dalam sereal (tepung gandum, oat), teh, kopi, kakao, dan kalsium.
Orang yang mengalami menstruasi dengan pendarahan yang banyak harus menemui dokter untuk mendapatkan pengobatan. Mencuci tangan dengan sabun dan air serta menggunakan toilet yang bersih juga penting untuk mengurangi risiko infeksi karena beberapa infeksi juga dapat menyebabkan anemia. Malaria juga dapat menyebabkan anemia. Masyarakat yang tinggal di daerah dengan kasus malaria yang sering terjadi harus mengikuti saran pencegahan dari otoritas kesehatan setempat.[2]
Baca Juga: Hb Meter POCT: Salah Pilih Bahayakan Nyawa!
Bagi Anda yang tengah mencari alat pengukur hemoglobin (HB Meter) Point of Care Testing (POCT) terpercaya dan telah mendapatkan rekomendasi WHO serta telah digunakan oleh Palang Merah Indonesia, silakan kunjungi halaman berikut untuk informasi lebih lanjut:
Referensi Artikel:
- Turner J, Parsi M, Badireddy M. Anemia. [Updated 2023 Aug 8]. In: StatPearls [Internet]. Treasure Island (FL): StatPearls Publishing; 2024 Jan-. Available from: https://www.ncbi.nlm.nih.gov/books/NBK499994/
- (2023). Anaemia. WHO. https://www.who.int/news-room/fact-sheets/detail/anaemia (diakses pada 25 APR 2024).
- Cappellini, M. D., & Motta, I. (2015). Anemia in Clinical Practice-Definition and Classification: Does Hemoglobin Change With Aging?. Seminars in hematology, 52(4), 261–269. https://doi.org/10.1053/j.seminhematol.2015.07.006
- Srakocic S., Brocato C. (2023). What Are the Different Types of Anemia?. healthline. https://www.healthline.com/health/anemia/types-of-anemia#summary (diakses pada 25 APR 2024).
- Maner BS, Moosavi L. Mean Corpuscular Volume. [Updated 2022 Jul 4]. In: StatPearls [Internet]. Treasure Island (FL): StatPearls Publishing; 2024 Jan-. Available from: https://www.ncbi.nlm.nih.gov/books/NBK545275/
- Chaudhry HS, Kasarla MR. Microcytic Hypochromic Anemia. [Updated 2023 Aug 14]. In: StatPearls [Internet]. Treasure Island (FL): StatPearls Publishing; 2024 Jan-. Available from: https://www.ncbi.nlm.nih.gov/books/NBK470252/
- Yilmaz G, Shaikh H. Normochromic Normocytic Anemia. [Updated 2023 Feb 24]. In: StatPearls [Internet]. Treasure Island (FL): StatPearls Publishing; 2024 Jan-. Available from: https://www.ncbi.nlm.nih.gov/books/NBK565880/
- Moore CA, Adil A. Macrocytic Anemia. [Updated 2022 Jul 11]. In: StatPearls [Internet]. Treasure Island (FL): StatPearls Publishing; 2024 Jan-. Available from: https://www.ncbi.nlm.nih.gov/books/NBK459295/.
- Barbara J. Bain, 5 – Blood Cell Morphology in Health and Disease, Editor(s): Barbara J. Bain, Imelda Bates, Michael A. Laffan, Dacie and Lewis Practical Haematology (Twelfth Edition),Elsevier, 2017, Pages 61-92, ISBN 9780702066962, https://doi.org/10.1016/B978-0-7020-6696-2.00005-9.
- GBD 2021 Anaemia Collaborators (2023). Prevalence, years lived with disability, and trends in anaemia burden by severity and cause, 1990-2021: findings from the Global Burden of Disease Study 2021. The Lancet. Haematology, 10(9), e713–e734. https://doi.org/10.1016/S2352-3026(23)00160-6
- Badan Penelitian dan Pengembangan Kesehatan Kementerian RI tahun 2018. (2018). Riset Kesehatan Dasar (Riskesdas) 2018. Kemenkes RI. https://layanandata.kemkes.go.id/katalog-data/riskesdas/ketersediaan-data/riskesdas-2018 (diakses pada 25 APR 2024).